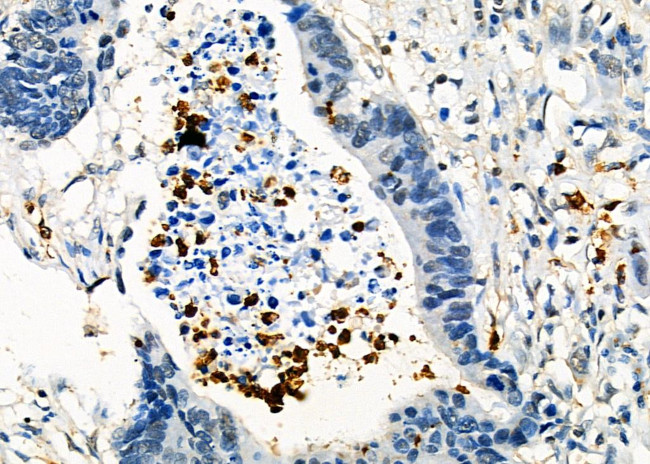
FGL2 Antibody in Immunohistochemistry (Paraffin) (IHC (P))

Search
Invitrogen
FGL2 Polyclonal Antibody
{{$productOrderCtrl.translations['antibody.pdp.commerceCard.promotion.promotions']}}
{{$productOrderCtrl.translations['antibody.pdp.commerceCard.promotion.viewpromo']}}
{{$productOrderCtrl.translations['antibody.pdp.commerceCard.promotion.promocode']}}: {{promo.promoCode}} {{promo.promoTitle}} {{promo.promoDescription}}. {{$productOrderCtrl.translations['antibody.pdp.commerceCard.promotion.learnmore']}}
图: 1 / 3
FGL2 Antibody (PA5-115230) in IHC (P)



Please note: We are reviewing Western blot images included in the antibody testing data in our catalog, including those provided by third parties. Unless expressly labeled or annotated as “raw-unedited”, Western blot images included in the antibody testing data in our catalog may have been edited, optimized or otherwise adjusted for presentation.
产品信息
PA5-115230
种属反应
宿主/亚型
分类
类型
抗原
偶联物
形式
浓度
规格
纯化类型
保存液
内含物
保存条件
运输条件
RRID
产品详细信息
Antibody detects endogenous levels of total Fgl2.
靶标信息
Fibrinogen-like protein 2 (Fgl2), also known as fibroleukin, is secreted by T cells and is involved in diseases in which thrombosis plays a pivotal role, such as virus-induced fulminant hepatitis, fetal loss syndrome and xenograft rejection. Constitutively expressed in cytotoxic T cells, Fgl2 exerts immunosuppressive effects on both T cell proliferation and dendritic cell maturation. Fgl2 is a serine protease and directly cleaves prothrombin to thrombin. Fgl2 functions in the pathogenesis of diseases including viral-induced hepatitis and Th1 cytokine-induced fetal loss syndrome.
仅用于科研。不用于诊断过程。未经明确授权不得转售。